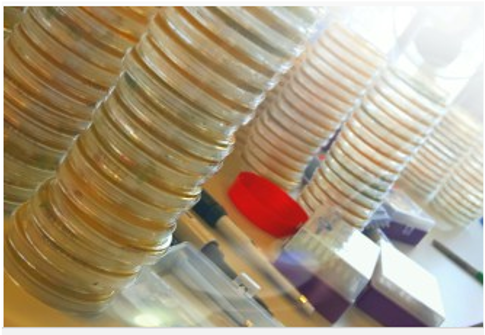

Antimicrobial Resistance – Bacteria in the blood of neonates
Published in Microbiology

A large international effort involving over 160 researchers, clinicians, nurses and data managers in their respective countries worked collaboratively to recover, identify and profile bacteria from neonates’ blood. Read our article here. The Burden of Antibiotics in Developing Societies (BARNARDS; http://barnards-group.com) involved twelve clinical sites in seven countries - four in Africa (Ethiopia, Nigeria, Rwanda and South Africa) and three in South Asia (Bangladesh, India and Pakistan). We worked with clinical teams in both urban and rural communities to capture key sociodemographic data to help build a picture of life for these mothers and neonates from diverse countries.

“New antimicrobial resistance mechanisms are emerging and spreading globally, threatening our ability to treat common infectious diseases, resulting in prolonged illness, disability, and death…More than one-third of the estimated four million newborn deaths around the world each year are caused by severe infections, and a quarter – around one million deaths – are due to neonatal sepsis/pneumonia alone.” – World Health Organization (WHO)
Many different types of bacteria were isolated from the blood samples. Historically, we have seen that bacteria-causing-sepsis in high income countries (e.g. UK and the USA) are different to bacteria from Africa and South Asia. For the latter, it is predominantly Gram-negative bacteria including Klebsiella and Escherichia along with other members of the family Enterobacterales. Bacteria evolve constantly, often sharing pieces of DNA that ultimately make them resistant to certain antibiotics. With more DNA, comes more resistance. Antibiotic resistance is a global threat yet our understanding of resistance levels in Africa and South Asia and how that impacts on therapy and patient outcome is poor. This situation is more problematic when dealing with critical populations such as septic neonates. The World Health Organisation (WHO) recommend the antibiotics ampicillin and gentamicin as the first line treatment for neonatal sepsis; however, 95% of bacteria recovered from the baby’s blood in our study were resistant to ampicillin, and 60% resistant to both antibiotics indicating that nearly 2/3 treatments are inappropriate. Notwithstanding, our study also provided valuable data on other, more potent, antibiotics that could potentially be used in the future with greater success.

A Sankey diagram showing the dominant bacterial species found, linking the plasmid types they carry and antibiotic resistance genes (Figure from Sands et al 2021, https://doi.org/10.1038/s41564-021-00870-7)
Blending together microbiology and whole genome sequencing, for the first time on this scale, we were able to characterise each of the bacteria grown from the neonates’ blood. How useful is this to help with the clinical problem? Until recently the scientific and medical community have had little opportunity to interrogate bacterial DNA data to determine how similar (or different) these bacteria are across multiple countries in both sub-Saharan Africa and in South Asia – where the majority of low and middle countries are situated. Did we find the same kinds of bacterial species, strains (genetic variant) in Nigeria, Ethiopia and Pakistan? We can build phylogenies to see how related they are. And we did. To make matters worse in an already challenging environment, during the study we detected at least five large outbreaks across four countries. Several hundreds of babies had sepsis directly related to a hospital outbreak. These bacteria often carried antibiotic resistance genes and therefore, unlikely to respond to key antibiotic treatments.
Here we emphasise two key messages. Firstly, antibiotic resistance in bacteria causing sepsis from the BARNARDS program is alarmingly high. Secondly, through consistent whole genome sequencing of all BARNARDS bacteria, we found a high diversity of bacterial species causing sepsis and reveal examples of intraspecies diversity and clustering (outbreaks).

Since 2015, BARNARDS is linking clinical, microbiological, genomic, and sociodemographic data between the mother, the neonate, the immediate surrounding healthcare environment and the wider living environment. Our research nurses worked tirelessly to inform mothers admitted to hospitals about the BARNARDS study, and to enrol and sample the mothers’ and their neonates’.
What other research are we doing in BARNARDS?
- To assess the impact of antibiotic resistant Gram-negative bacteria carried as normal microbiota in mothers and neonates in the development of neonatal sepsis. For this, isolates from baby blood samples and isolates from rectal samples of the babies and of the mothers of those babies (septic cases) are subjected to whole genome sequencing (WGS) to provide strain type, virulence related genes, type and number of ARG and major plasmid mob genes – this behind the paper post focuses on the bacteria from the babies’ blood.
- To identify routes of transmission of antibiotic resistant Gram-negative bacteria within each site. This is being addressed by additional characterisation of bacterial isolates recovered from environmental samples.
Collectively, BARNARDS will assess the impact and burden of antimicrobial resistance on clinical outcomes of neonates whilst determining local and common risk factors to identify potential intervention studies.
BARNARDS enrolled over 35,000 mothers and we would like to take this opportunity to thank them, their families and all the BARNARDS clinical and local staff who formed an incredible, globally unique, network to capture vital epidemiological data that enriched our microbiological and molecular analysis.

Follow the Topic
-
Nature Microbiology
An online-only monthly journal interested in all aspects of microorganisms, be it their evolution, physiology and cell biology; their interactions with each other, with a host or with an environment; or their societal significance.






Please sign in or register for FREE
If you are a registered user on Research Communities by Springer Nature, please sign in